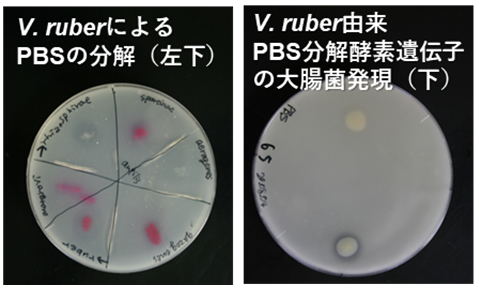

「Japan Mobility Show 2025」初出展のご報告
 ロッテホールディングス
ロッテホールディングス ロッテホールディングス
ロッテホールディングス メディカルクリエーションふくしま
メディカルクリエーションふくしま ロッテホールディングス
ロッテホールディングス daiya co.,ltd
daiya co.,ltd ハンファジャパン株式会社
ハンファジャパン株式会社 株式会社グリーンレイズ輻射空調エンジニアリング
株式会社グリーンレイズ輻射空調エンジニアリング 大日本印刷(DNP)
大日本印刷(DNP) 株式会社商船三井
株式会社商船三井 株式会社pP
株式会社pP エア・ウォーター株式会社
エア・ウォーター株式会社 株式会社商船三井
株式会社商船三井 RX Japan株式会社
RX Japan株式会社 公益財団法人 横浜市芸術文化振興財団
公益財団法人 横浜市芸術文化振興財団 株式会社ホットアルバム炭酸泉タブレット
株式会社ホットアルバム炭酸泉タブレット CACL
CACL 伯東株式会社
伯東株式会社 株式会社ヴァーチェ
株式会社ヴァーチェ 株式会社ホットアルバム炭酸泉タブレット
株式会社ホットアルバム炭酸泉タブレット 株式会社BIOTECHWORKS-H2
株式会社BIOTECHWORKS-H2 株式会社BIOTECHWORKS-H2
株式会社BIOTECHWORKS-H2 株式会社イトーキ
株式会社イトーキ &be
&be 有限会社やまぎん
有限会社やまぎん 有限会社やまぎん
有限会社やまぎん 株式会社ジェイシーレゾナンス
株式会社ジェイシーレゾナンス 株式会社ビューティーカレンダー
株式会社ビューティーカレンダー 株式会社きものブレイン
株式会社きものブレイン 株式会社ジュン
株式会社ジュン 三菱ケミカル
三菱ケミカル レゾナック・ホールディングス
レゾナック・ホールディングス 株式会社きものブレイン
株式会社きものブレイン 有限会社やまぎん
有限会社やまぎん &be
&be &be
&be 株式会社Ci
株式会社Ci 株式会社OOHAAH
株式会社OOHAAH &be
&be 株式会社OOHAAH
株式会社OOHAAH 株式会社レビュー
株式会社レビュー 日本経済新聞社
日本経済新聞社